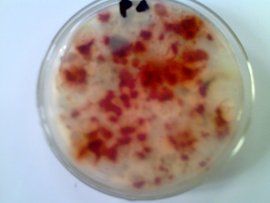
PDA培養基 PDA培養基

特點及用途
分裝於試管一種常用的培養基,宜培養酵母菌、黴菌、蘑菇等真菌。
按物理性狀劃分:固體培養基
按培養基成分劃分:半合成培養基
配製方法
配方
馬鈴薯 200克 葡萄糖 20克
瓊脂 15~20克 自來水 1000毫升
自然PH
配製步驟
煮馬鈴薯塊其做法是先洗淨去皮,再稱取200g馬鈴薯切成小塊,加水煮爛(煮沸20~30分鐘,能被玻璃棒戳破即可),用八層紗布過濾,加熱,再據實際實驗需要加1-10g瓊脂,繼續加熱攪拌混勻,待瓊脂溶解完後,加入葡萄糖,攪拌均勻,稍冷卻後再補足水分至1000毫升,分裝試管或者錐形瓶,加塞、包紮,(121℃)滅菌20分鐘左右後取出試管擺斜面或者搖勻,冷卻後貯存備用。
其他事項
1.培養基經滅菌後,必須放在37C溫箱培養24h,無菌生長者方可使用。
2.PDA培養基一般不需要調pH。對於要調節pH的培養基,一般用pH試紙測定其pH。如果培養基偏酸或偏鹼時,可用lmol/LNaOH或lmol/LHCL溶液進行調節。調節時應逐滴加入NaOH或HCl溶液,防止局部過酸或過鹼破壞培養基成分。
3.培養基在使用時也可以做成不含瓊脂的液體培養基,用於菌類的震盪培養。
4.培養基也可以加入氯黴素或土黴素,加入量為0.2g/L培養基,主要是為了抑制細菌的生長,減少干擾性
PDA培養基的配製
(1)稱量和熬煮
按培養基配方逐一稱取去皮土豆。土豆切成小塊放入鍋中,加水1000ml,在加熱器上加熱至沸騰,維持20-30min,用可用2層紗布趁熱在量杯上過濾,濾渣棄取。濾液補充水分到1000ml。
(2)加熱溶解
把濾液放入鍋中,加入葡萄糖20g,瓊脂15~20g(提前搞碎),然後放在石棉網上,小火加熱,並用玻棒不斷攪拌,以防瓊脂糊底或溢出,待瓊脂完全溶解後,再補充水分至所需量。
(3)分裝
按實訓要求,將配製的培養基分裝入試管或500ml三角瓶內。分裝時可用三角漏斗以免使培養基沾在管口或瓶口上造成污染。
分裝量:固體培養基約為試管高度的1/5,滅菌後製成斜面,分裝入三角瓶內以不超過其容積的一半為宜;半固體培養基以試管高度的1/3為宜,滅菌後垂直待凝。
(4)加棉塞
培養基分裝完畢後,在試管口或三角燒瓶口上塞上棉塞(或泡沫塑膠塞或試管帽等),以阻止外界微生物進入培養基內造成污染,並保證有良好的通氣性能。
(5)包紮
加塞後,將全部試管用麻繩或橡皮筋捆好,再在棉塞外包一層牛皮紙,以防止滅菌時冷凝水潤濕棉塞,其外再用一道線繩或橡皮筋紮好,用記號筆註明培養基名稱、組別、配製日期。
棉塞製作說明
棉塞的作用:一是防止雜菌污染;二是可過濾空氣,保證通氣良好,並可減緩培養基水分的蒸發,所以正確地製備棉塞是培養基製備中重要的一環。
正確的棉塞是形狀、大小,鬆緊應與試管口(或三角燒瓶)完全適合。過緊則妨礙空氣流通,操作不便;過松時,空氣會毫無障礙地進入試管(或三角燒瓶)中,達不到滅菌的目的。棉塞過小往往易掉進試管內,因此棉塞質量的優劣對實訓的結果有很大的影響。正確的棉塞頭較大,加塞時,應使棉塞長度的1/3留在試管口外,2/3在試管口內。目前,有條件的實訓室已使用堅固的塑膠試管帽、金屬試管帽、矽膠泡沫塞替代棉塞,製作棉塞要選纖維較長的棉花,一般不選用脫脂棉。因為它容易吸水變濕,造成污染,而且價格也貴